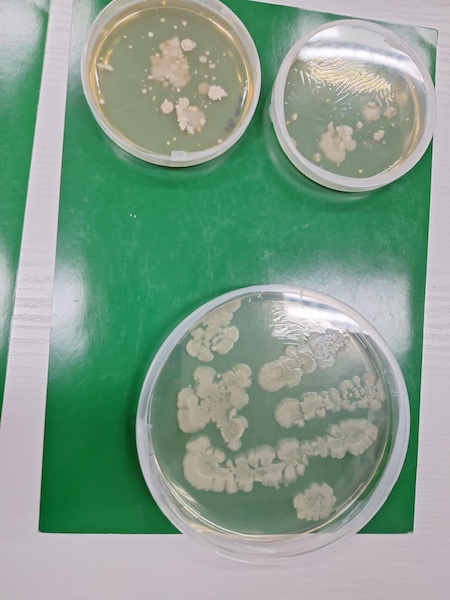

"Noc Biologów" w UMCS

W dniu 10 stycznia 2025 roku Mateusz Sokal, uczeń klasy 2h, reprezentował I Liceum Ogólnokształcące, uczestnicząc w warsztatach laboratoryjnych oraz wykładach zorganizowanych przez Wydział Biologii i Biotechnologii Uniwersytetu Marii Curie-Skłodowskiej w ramach wydarzenia "Noc Biologów".
Celem tego wydarzenia było rozwijanie praktycznych umiejętności biochemicznych uczniów, takich jak obsługa mikroskopów, tworzenie preparatów mikroskopowych, zakładanie hodowli bakterii, badanie organelli komórkowych, budowa biologicznych półogniw oraz analiza komórek nowotworowych. Dodatkowo warsztaty miały na celu poszerzenie wiedzy uczestników w zakresie ich pasji.
Program warsztatów obejmował szeroką gamę zagadnień, w tym wirusologię, mikrobiologię, onkologię, transplantologię, immunologię, biofizykę oraz genetykę. Wydarzenie stanowiło wyjątkową okazję do pogłębiania wiedzy i zdobycia nowych doświadczeń w dziedzinach biologii i biotechnologii.